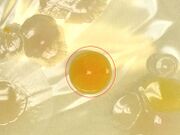
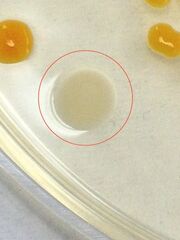

Uploads by Shauna McManus
From OpenWetWare
Jump to navigationJump to search
This special page shows all uploaded files.
| Date | Name | Thumbnail | Size | Description |
|---|---|---|---|---|
| 02:56, 9 March 2015 | Heartbeat.MOV (file) | 14.18 MB | ||
| 02:54, 9 March 2015 | Test 3 ed.jpg (file) |  |
34 KB | |
| 02:54, 9 March 2015 | More crooked ed.jpg (file) |  |
31 KB | |
| 02:54, 9 March 2015 | Crooked ed.jpg (file) |  |
29 KB | |
| 02:50, 9 March 2015 | Test 3.jpg (file) |  |
1.73 MB | |
| 02:50, 9 March 2015 | More crooked.jpg (file) |  |
1.54 MB | |
| 02:50, 9 March 2015 | Crooked.jpg (file) |  |
1.55 MB | |
| 19:44, 8 March 2015 | Day 15.png (file) |  |
77 KB | |
| 19:44, 8 March 2015 | Day 8.png (file) |  |
63 KB | |
| 19:44, 8 March 2015 | Day 13.png (file) |  |
74 KB | |
| 19:44, 8 March 2015 | Day 10.png (file) |  |
67 KB | |
| 19:44, 8 March 2015 | Day 6.png (file) |  |
52 KB | |
| 19:44, 8 March 2015 | Day 3.png (file) |  |
24 KB | |
| 04:06, 28 February 2015 | Bacterial chart 2.png (file) |  |
64 KB | |
| 03:35, 28 February 2015 | Bacterial chart.png (file) |  |
63 KB | |
| 02:35, 28 February 2015 | Pcr gel.jpg (file) |  |
42 KB | |
| 02:53, 25 February 2015 | Vertebrate1.png (file) |  |
88 KB | |
| 06:06, 17 February 2015 | Squid.jpeg (file) |  |
37 KB | |
| 06:06, 17 February 2015 | Spider.jpeg (file) |  |
40 KB | |
| 06:06, 17 February 2015 | Invertebrate.png (file) |  |
55 KB | |
| 15:19, 11 February 2015 | Table two a.png (file) |  |
31 KB | |
| 15:19, 11 February 2015 | Table three a.png (file) |  |
11 KB | |
| 15:19, 11 February 2015 | Table one a.png (file) |  |
91 KB | |
| 15:15, 11 February 2015 | Table three.png (file) |  |
9 KB | |
| 15:15, 11 February 2015 | Table two.png (file) |  |
18 KB | |
| 15:15, 11 February 2015 | Table one.png (file) |  |
45 KB | |
| 15:12, 11 February 2015 | Fig six.jpg (file) |  |
45 KB | |
| 15:12, 11 February 2015 | Fig seven.jpg (file) |  |
59 KB | |
| 15:12, 11 February 2015 | Fig three.jpg (file) |  |
37 KB | |
| 15:12, 11 February 2015 | Fig four.jpg (file) |  |
32 KB | |
| 15:12, 11 February 2015 | Fig five.jpg (file) |  |
32 KB | |
| 15:11, 11 February 2015 | Fig two.jpg (file) |  |
30 KB | |
| 15:11, 11 February 2015 | Fig one.jpg (file) |  |
27 KB | |
| 04:15, 3 February 2015 | Bacteria4.JPG (file) |  |
32 KB | |
| 04:15, 3 February 2015 | Bacteria3.JPG (file) |  |
31 KB | |
| 04:15, 3 February 2015 | Bacteria-2.JPG (file) |  |
18 KB | |
| 04:15, 3 February 2015 | Bacteria1.JPG (file) |  |
17 KB | |
| 04:15, 3 February 2015 | TABLE2.png (file) |  |
76 KB | |
| 04:14, 3 February 2015 | Colony-4.jpeg (file) |  |
30 KB | |
| 04:14, 3 February 2015 | Colony-2.jpeg (file) | |
40 KB | |
| 04:14, 3 February 2015 | Colony-1.jpeg (file) |  |
34 KB | |
| 04:13, 3 February 2015 | Colony-3.jpeg (file) | |
39 KB | |
| 04:10, 3 February 2015 | TABLE1.png (file) |  |
22 KB | |
| 04:09, 3 February 2015 | Hay infusion -1.jpeg (file) |  |
35 KB | |
| 04:08, 3 February 2015 | Hay infusion -2.jpeg (file) |  |
36 KB | |
| 03:22, 27 January 2015 | Fig9.JPG (file) |  |
24 KB | |
| 03:22, 27 January 2015 | Fig8.JPG (file) |  |
19 KB | |
| 03:21, 27 January 2015 | Fig7.JPG (file) |  |
13 KB | |
| 03:20, 27 January 2015 | Fig6.JPG (file) |  |
19 KB | |
| 03:16, 27 January 2015 | Fig 5.JPG (file) |  |
28 KB |